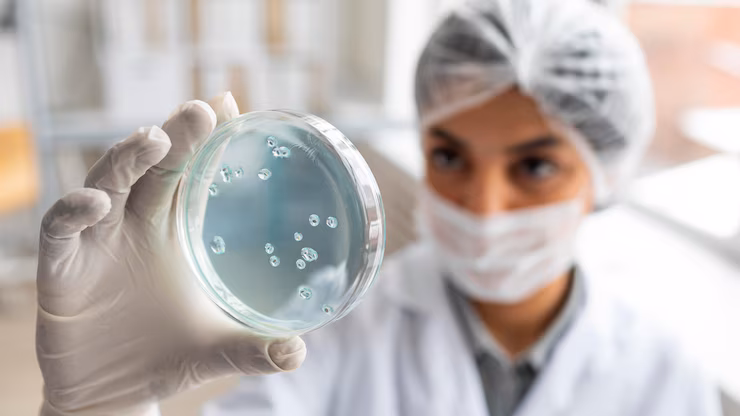

Só DIETA não resolve!
EXCLUSIVO: Descubra a Bactéria-Chave da Sua Microbiota que Regula o Intestino, Aumenta a Imunidade e Ainda Te Faz Emagrecer.
A produção científica sobre a microbiota intestinal tem crescido de forma acelerada nos últimos anos, alcançando um recorde de citações em 2024 e se estendendo até os dias atuais, segundo dados do PubMed — a maior base de pesquisas da área da saúde.
Por Ana Moraes
15/08/2025 - Atualizado há 2 horas

Reportagem Nova TV – Todos direitos reservados
Dados atualizados provenientes de estudos científicos publicados nas maiores bases de pesquisa.
Sua Microbiota!
Por National Center For Biotechnology Information
Você já parou para pensar que dentro de você existe um universo inteiro? Um ecossistema complexo, repleto de trilhões de microrganismos que influenciam diretamente sua saúde, seu humor e até mesmo sua capacidade de emagrecer?
Estamos falando da sua microbiota intestinal, um exército invisível de bactérias, fungos, vírus e outros seres microscópicos que habitam seu intestino. Quando essa comunidade está em harmonia, tudo funciona como um relógio suíço. Mas, e quando o caos se instala?
O Lado Sombrio da Desregulação: As "Dores" que Ninguém Te Conta
Imagine sentir um desconforto constante no abdômen, um inchaço que impede o uso de suas roupas favoritas, ou até mesmo idas frequentes ao banheiro, sem entender o motivo. Essas são apenas algumas das dificuldades que milhões de pessoas enfrentam diariamente por causa de uma microbiota desregulada.
"Eu vivia com dores terríveis, gases e uma fadiga que não me deixava fazer nada", relata Maria, uma paciente que lutou anos para encontrar um diagnóstico. "Nenhum médico conseguia entender o que estava acontecendo comigo. Me sentia perdida e desesperada."
E a história de Maria não é um caso isolado. A dificuldade em encontrar um diagnóstico preciso, a frustração com tratamentos ineficazes e a luta para manter uma dieta saudável são obstáculos comuns para quem sofre com o desequilíbrio da microbiota.
Veja a diferença entre uma microbiota regulada e uma desregulada.

Durante o processo de pesquisa e descobertas...
Conversei com dois pesquisadores brasileiros que estão conduzindo estudos inovadores sobre a microbiota intestinal. Além disso, mergulhei em diversos trabalhos científicos para entender o que realmente influencia o funcionamento do nosso intestino — e como ele pode ser a chave para a saúde e o emagrecimento natural.
Os Vilões da Microbiota: Uma Ameaça Silenciosa
Mas, o que causa essa desordem no nosso intestino? A resposta é complexa, mas alguns fatores são cruciais:
Dieta Inadequada: O consumo excessivo de alimentos processados, açúcares e a falta de fibras prejudicam sua microbiota.
Antibióticos: O uso indiscriminado desses medicamentos pode eliminar bactérias benéficas, favorecendo o desequilíbrio.
Estresse Crônico: A rotina agitada e a pressão constante podem afetar a saúde do seu intestino, alterando sua microbiota.
Doenças Crônicas: Condições como diabetes, obesidade e doenças inflamatórias intestinais também contribuem para a desregulação.

Como o Uso de Antibióticos Pode Desestabilizar Sua Saúde Intestinal
O curioso é que esse problema frequentemente começa com o uso excessivo de antibióticos e uma alimentação rica em gorduras. Mas como os medicamentos influenciam nesse processo?
Os antibióticos são usados para combater infecções bacterianas, mas, ao fazer isso, acabam afetando a microbiota intestinal de forma geral. Esse desequilíbrio pode prejudicar até mesmo as bactérias benéficas para o emagrecimento, como as que ajudam na digestão e no controle do apetite. Ao abalarem a microbiota como um todo, os antibióticos criam brechas para o crescimento de bactérias oportunistas, que podem dificultar ainda mais a perda de peso.
Esse tipo de desequilíbrio na microbiota é uma das razões pelas quais especialistas, incluindo a Organização Mundial da Saúde (OMS), defendem o uso mais responsável dos antibióticos. O uso indiscriminado pode prejudicar ainda mais o equilíbrio do corpo e abrir caminho para outros problemas de saúde.
Pesquisas recentes têm demonstrado que pessoas com depressão frequentemente apresentam uma microbiota menos diversificada, com menor quantidade de bactérias benéficas. Em contrapartida, estudos com probióticos (suplementos de bactérias benéficas) têm mostrado resultados promissores na redução dos sintomas depressivos em alguns casos.
O Futuro da Saúde Mental: Modulando a Microbiota
Diante dessas descobertas, a modulação da microbiota emerge como uma nova e promissora estratégia no tratamento da depressão. Através de mudanças na dieta, uso de probióticos e prebióticos (alimentos que nutrem as bactérias benéficas), os cientistas esperam equilibrar a microbiota e, consequentemente, melhorar o humor e a saúde mental.
O Que Você Pode Fazer Agora
Embora a pesquisa ainda esteja em andamento, já existem medidas que você pode tomar para cuidar da sua microbiota e, potencialmente, melhorar o seu bem-estar mental:
Alimente-se de forma saudável: Priorize alimentos ricos em fibras, como frutas, verduras, legumes e grãos integrais.
Considere probióticos: Consulte um profissional de saúde para avaliar a necessidade de suplementação com probióticos.
Reduza o estresse: O estresse crônico pode afetar negativamente a microbiota.
Consulte: Guias Informativos, que darão dicas e receitas para o seu dia a dia.
A microbiota desregulada é um dos grandes obstáculos silenciosos no processo de emagrecimento. Ela afeta diretamente o metabolismo, altera hormônios da saciedade e da fome, causa inflamações e promove o acúmulo de gordura — especialmente na região abdominal. O resultado? Dificuldade para perder peso, mesmo com dieta e exercícios.
Mas a boa notícia é que, com as estratégias certas, é possível reequilibrar essa comunidade de microrganismos e acelerar naturalmente o processo de emagrecimento. A chave está em adotar hábitos alimentares que favoreçam as bactérias benéficas, utilizar suplementos quando necessário e, principalmente, incluir receitas naturais que realmente funcionam, como sucos com ingredientes fermentados, iogurtes probióticos caseiros, vegetais ricos em fibras e preparações com alimentos fermentados que alimentam as boas bactérias do intestino.
Mas que bactéria é essa que vem despertando tanto interesse da ciência?
Ela tem mostrado um papel promissor na regulação do peso corporal, na melhora da sensibilidade à insulina e na redução da inflamação intestinal. Já, já vamos revelar qual é, mas antes, é importante entender que não existe milagre em uma única bactéria. O emagrecimento sustentável depende do equilíbrio da microbiota como um todo — e não de uma solução isolada.
É fundamental que mais pessoas — inclusive profissionais de saúde e instituições — passem a enxergar a microbiota como aliada no combate à obesidade. Quando cuidamos do intestino, abrimos caminho para um corpo mais leve, saudável e equilibrado.

Aqui terminam as dores. E também a frustração de não ver os resultados que você tanto merece.
Com tudo isso, assim como Maria cansou de viver uma vida cheia de dores e frustração por não conseguir emagrecer, nós também não conseguimos aceitar que tantas pessoas continuassem presas nesse ciclo. Depois da entrevista com ela, decidimos ir mais fundo. Fomos atrás de pesquisas, de especialistas, de respostas reais — não só para ajudar a Maria, mas para ajudar todos que vivem a mesma dor e sentem a mesma frustração diariamente.
E foi aí que tudo começou a mudar.
Maria antes e depois: o resultado de uma escolha simples, mas poderosa.
Com pequenas mudanças na alimentação, foco nos alimentos certos e o apoio das estratégias do nosso guia, Maria não só perdeu peso — ela ganhou energia, autoestima e leveza no dia a dia.
É gratificante ver esse resultado.
Maria tirou um peso da consciência — e não estamos falando só dos quilos perdidos, mas de uma vida mais equilibrada.
Hoje, ela se sente mais disposta, dorme melhor e tem orgulho do reflexo que vê no espelho.
Ela não se cobra mais como antes, porque finalmente alcançou o resultado que buscava há anos: bem-estar de verdade.
E o que fez toda essa transformação acontecer?
Depois de tantas tentativas frustradas, o segredo estava em algo que quase ninguém fala: uma bactéria poderosa chamada Akkermansia muciniphila.
Com o guia certo, Maria conseguiu ativar essa bactéria no intestino — e seu corpo respondeu de forma surpreendente.

Mas afinal… o que torna a Akkermansia tão especial?
Ela pode até ter um nome difícil de lembrar, mas seus efeitos no corpo são inesquecíveis.
A Akkermansia muciniphila é uma bactéria do bem, que vive no intestino e tem um papel crucial no emagrecimento, na saúde intestinal e no controle da inflamação.
Estudos mostram que pessoas com bons níveis dessa bactéria tendem a ter menos gordura abdominal, mais energia e um metabolismo mais ativo.
Ela ajuda a fortalecer a barreira intestinal, reduz a resistência à insulina e contribui para uma digestão mais eficiente.
Sabe aquele fenômeno que a gente sempre comenta?
Aquelas pessoas que comem de tudo e não engordam por nada?
Pois é… muitas delas têm altos níveis de Akkermansia naturalmente ativos no corpo.
É como se o metabolismo funcionasse a favor delas o tempo todo — e agora, você também pode despertar isso dentro de você.
E o melhor de tudo?
Você não precisa de medicamentos ou suplementos caros para estimular essa bactéria no seu organismo.
Com os alimentos certos, hábitos simples e as estratégias práticas que você vai encontrar neste guia, é totalmente possível ativar a Akkermansia naturalmente — assim como a Maria fez.
✨ Pronta pra transformar o seu corpo de dentro pra fora?
Se você acompanhou esta reportagem até aqui, agora tem a oportunidade de dar o próximo passo.
O eBook "Descubra como restaurar sua microbiota intestinal, reduzir inflamações e ativar o emagrecimento" explica, de forma prática, como ativar sua microbiota para conquistar resultados duradouros.

Você precisa estar logado para comentar.
4 comentários
·
·
·
·
·
·
·
·
·
·
·
·
·
·
·
·
·
·
·
·
·
Plugin de comentários do Facebook
Tooltip content